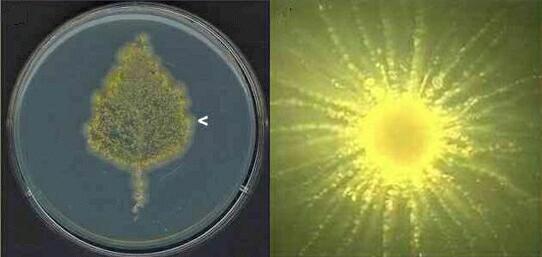

..
IMAGES FROM CHAPTER 11: FUNGAL ECOLOGY - SAPROTROPHS
Fig 11.1 A method of defining the life-history strategy of a fungus according to its degree of expression of the three ‘primary strategies’ – ruderal behaviour (R), K-selected or combative behaviour (K/C) and stress-tolerance.
Fig 11.2
Ganoderma adspersum, a fungus that progressively
rots the heartwood of standing trees (especially beech, Fagus
sylvatica) and produces woody, perennial, hoof-like
fruitbodies which release millions of spores. The current
year’s young growth is white. [© Jim
Deacon]
Fig 11.3 Examples of some fluorescent vital dyes. When these dyes are pre-loaded into fungal hyphae the dyes can be used to trace the growth of fungi in natural substrates such as soil. (a) Hyphae of Sclerotium cepivorum treated with CMFDA, which accumulates in fungal vacuoles and shows as bright green fluorescence. (b) Hyphae and spores of Pythium oligandrum, stained with Cellufluor which binds to chitin in fungal walls and fluoresces blue. (c) Hyphae of Fusarium oxysporum stained with DiI and DiO, giving green or red fluorescence of the fungal membranes. (d) Hyphae of Botrytis cinerea stained with CMAC, giving blue fluorescence of the vacuoles. (e) Hyphae of Fusarium oxysporum stained with Nile red, showing intense yellow fluorescence of lipid droplets, while the cytoplasm fluoresces orange. [© A. Stewart & Jim Deacon]
Fig 11.4 Nuclei fluorescing blue in a hypha stained with the nucleus-specific dye, DAPI [The interference lines were caused by capturing the image on a video monitor] [© Jim Deacon]
Fig 11.5 Representation of the overlapping phases of activity of different types of fungi in a decomposition sequence. [© Jim Deacon]
Fig 11.6 Left: leaf print of a mature birch leaf, incubated on agar, showing a predominance of a yellow Candida-like fungus that produced a fringe of hyphae from the leaf margin (arrowhead). Right, a single colony of the Candida-like fungus, showing widely spaced radiating hyphae with clusters of yeast-like cells at intervals along the hyphae. [© Jim Deacon]
Fig 11.7 An assortment of darkly pigmented spores of fungi that typically colonise the dead or dying tissues of stem bases and the above-ground parts of senescing leaves and stems [© Jim Deacon]
Fig 11.8 Darkly pigmented sapstain fungi growing in the medullary rays of felled trees. [© Jim Deacon]
Fig 11.9 A small piece of transparent cellulose film (about 3 x 2 cm) retrieved from soil and stained with trypan blue to show fungi growing at different levels in the film. Rhizophlyctis rosea produces finely branched rhizoidal systems. At a different plane of focus, Pythium graminicola produces finger-like branching systems. [© Jim Deacon]
Fig 11.10 Top row: Part of a fairy ring caused by Marasmius oreades (left), and part of the turf lifted to show the mass of white fungal hyphae just below the soil surface (centre). A ring of small toadstools of Marasmius (right) develops near the killing zone in autumn. Bottom row: Left: close-up of two fruitbodies of Marasmius, showing the typical widely-spaced gills. Right: Toadstools of another fairy-ring fungus – the waxy, scarlet-coloured Hygrocybe sp. These toadstools form rings of fruitbodies but they do not kill the turf. [© Jim Deacon] |
|||||||||||